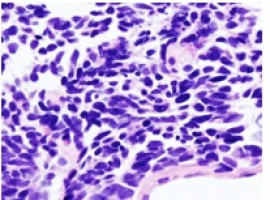
Study suggests surgery after imatinib therapy improves survival for metastatic or recurrent GIST

A new retrospective study reports that patients who underwent surgery to remove residual tumours after imatinib therapy had significantly improved overall survival and progression-free survival compared with those that received imatinib therapy alone.
“Many clinicians think that adding surgery is beneficial to the patient if the patient is responsive to imatinib, but the clinical evidence for this is very scarce,” said lead author Seong Joon Park, MD, a fellow at Asan Medical Center in Seoul, South Korea. “This study suggests that surgery offers a substantial survival benefit for patients with metastatic or recurrent GIST.”
Gastrointestinal stromal tumours (GISTs) arise most frequently in the stomach and small intestine, but can be found anywhere in or near the gastrointestinal tract.
Approximately 5,000 new cases of GIST are diagnosed in the United States each year.
The targeted drug imatinib is typically used as the first treatment for metastatic or recurrent GIST, and about 80-85 percent of patients respond to this treatment.
Although most patients with metastatic and recurrent GIST initially respond to imatinib treatment, most of them have residual tumour lesions despite continuing the treatment.
These residual tumours are believed to contribute to development of resistance to imatinib, so surgery to remove remaining tumour tissue had been anticipated to prolong survival.
The present study included patients with metastatic or recurrent GIST that were treated with imatinib alone (92 patients) or imatinib plus surgery to remove residual tumour lesions (42 patients).
The progression-free survival in the imatinib and surgery plus imatinib groups was 42.8 months and 87.7 months, respectively.
And overall survival was also significantly better among patients who received surgery ─ patients in the imatinib plus surgery group had a 5.5 fold lower risk of death.
Park says that residual lesions can be surgically removed in about a third of patients, and the decision to perform surgery is dependent on tumour and patient characteristics (e.g., tumour size).
Based on previous retrospective trials, there has been a consensus among experts that adding surgical removal of residual tumour lesions to imatinib therapy for patients with GIST that are responsive to imatinib is beneficial.
However, those previous studies did not provide sufficient evidence that surgery is beneficial because they assessed clinical outcomes only in patients who had received surgery. To evaluate the role of surgical resection in patients with GIST, it is necessary to compare the clinical outcomes of between patients who received surgery and imatinib and those who received imatinib only, which was done in the present study. Investigators also confirmed that having a low initial tumour burden was associated with longer overall survival.
Low initial tumour burden, female gender, and a specific alteration in the KIT gene were also associated with delayed disease progression. Patients with this KIT alteration typically have better response to imatinib therapy.
Source: ASCO